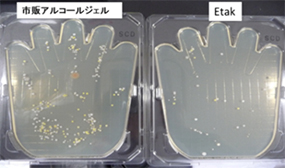
12時間後時点での比較

inter-edu’s eye
受験シーズン真っただ中の今、一番気をつけたいことは健康管理です。うっかり試験会場などで風邪をうつされ、第一志望はもとより、チャレンジ校や押さえ校の試験までもが台無しになることほど、お子さまにとってつらいことはありません。風邪やインフルエンザの予防法のひとつはマスクの着用です。マスクをより効果的に使い、お子さまをウイルス・菌から守りましょう。 連載第1回「本番で力を発揮するための風邪予防法」を見る ▶▶▶▶▶▶▶
inter-edu’s eye
受験シーズン真っただ中の今、一番気をつけたいことは健康管理です。うっかり試験会場などで風邪をうつされ、第一志望はもとより、チャレンジ校や押さえ校の試験までもが台無しになることほど、お子さまにとってつらいことはありません。風邪やインフルエンザの予防法のひとつはマスクの着用です。マスクをより効果的に使い、お子さまをウイルス・菌から守りましょう。
連載第1回「本番で力を発揮するための風邪予防法」を見る ▶▶▶▶▶▶▶


みなさんはマスクをどのように使っていますか? インターエデュが実施したアンケートによると、「マスクのサイズや機能、使い方にこだわりがある」との回答が89%と圧倒的な割合を占める結果となりました。その内訳を見てみると、「顔のサイズに合ったマスクを選んている」人が23%と最も多く、「正しいマスクの着け方を守っている」人が16%と続いています。確かに、風邪やインフルエンザが流行する時期にマスクを着用して外出することは、もはや一般的になったと言えるでしょう。ところが、次のアンケートでは驚くべき結果が明らかになりました。


体調管理が大事な受験シーズン中は、学校や塾でもお子さまの必需品となっているマスクですが、アンケート結果では、風邪やインフルエンザの予防効果を「70%以上期待できる」と答える人がわずか11%となっています。単に、マスクを着けただけではウイルスや菌を防げないと考えているのがエデュママの本音のようです。お子さまの頑張りが試されるこの時期に、万が一の体調不良で実力が発揮できないということだけは絶対に避けたいと考えて、慎重になるのは当然です。

ちょっとしたお出かけ先でも、手に付いた汚れや菌をサッと取り除けるハンドジェルやウェットティッシュなどを使用するのが日常的になってきました。そんな中で、除菌・防菌の効果を期待できるアイテムへの関心が高くなっています。最後のアンケートによると、「マスクにウイルス・菌の付着を防ぐ商品を使いたい」人が58%と大半を占める結果になりました。
マスクにはこだわりがあるけれども、それだけでは予防作用に不安があり、プラスアルファの除菌・防菌作用を求めるエデュママの姿が、一連のアンケート結果から見えてきました。
そこで、受験シーズンを迎えたお子さまやサポートを頑張る家族が使用するマスクに数回スプレーをするだけの、より安心な防菌スプレーを紹介します。



マスクで風邪やインフルエンザの予防作用を高めるためには、どうすればよいのでしょうか? 先ほどのアンケート結果から、ウイルス・菌の付着を防ぐ商品の使用について、関心は高いけれど、実際に使っている人は少ないことがわかりました。そこで、今、注目の防菌・防ウイルス作用成分「Etak」(読み方:イータック)を使用した防菌スプレー「クリスタルヴェール マスク防菌24」を開発した、エーザイ株式会社 薬粧事業部のみなさんに、マスク用の除菌・防菌スプレーを使ってウイルス・菌から、エデュママがお子さまを守る方法をうかがいました。
インターエデュ(以下、エデュ):マスクへのウイルス・菌対策は、どのようなものがあるのでしょうか?
エーザイ株式会社 薬粧事業部(以下、エーザイ):市販されているものに、「除菌スプレー」があります。スプレーすれば、マスクの表面に着いたウイルス・菌を取り除くことができますよ。しかし、単なる「除菌スプレー」では、新たにウイルス・菌が付着することを防げません。そのため、適宣、マスクにスプレーする必要があります。
エデュ:受験生のお子さま自身が、常にスプレーするのは、少し大変そうですね。
エーザイ:そこで今、注目されているのが、Etakを使った製品です。Etakは、吹き付けたものに除菌成分を留める特性があり、防菌・防ウイルス作用が24時間続き、スプレー後も新たにウイルス・菌が付着するのを防ぎます。お子さまのお出かけ前に、お母さまがマスクの表裏両面にスプレーしてあげれば、お子さまは安心して試験に挑めるでしょう。
エデュ:体調を万全にしなければいけない大事な時期に、お母さまがお子さまをサポートするには、作用の持続性がある製品を選ぶことが重要なのですね!

■12時間後時点での比較
市販のアルコールジェルとEtakの防菌・防ウイルス作用を比較した実験では、Etakの方が長時間、菌・ウイルスの増殖を抑制していることが明らかになりました。
エデュ:Etakの防菌・防ウイルス作用は、どのくらい持続するのですか?
エーザイ:実験では、数日間も防菌作用が続くことが分かっています。市販されているものなら、私たちが開発した防菌スプレー「クリスタルヴェール マスク防菌24」が、ウイルス・菌を24時間は寄せ付けません。Etakは、もともと歯科用に開発された成分なので、安全性についても徹底的に試験を繰り返し、評価されています。
エデュ:それなら、お子さまのマスクに使う時も、安心ですね!
エーザイ:私たちは常にウイルスの影響をチェックしています。冬は乾燥しやすいため、くしゃみなどで飛び散った飛沫から水分が抜け、ウイルス・菌だけが空気中に漂いやすくなります。空気中のウイルス・菌を吸い込まないためにも、マスクをより効果的に使い、万全の態勢でお子さまを試験会場に送り出してあげてください。


歯科などで使用されているEtakを、お母さまやお子さまでも手軽に使用できるように開発されたのが、マスク用の防菌スプレー「クリスタルヴェール マスク防菌24」です。2月は風邪やインフルエンザが流行る季節。Etakでマスクへのウイルス・菌の付着を防ぎ、マスクを使った予防をより効果的にしましょう!

※本製品は医薬品・医薬部外品ではありません。
※すべてのウイルス・菌に対して作用があるわけではありません。
エーザイ株式会社 薬粧事業部からのワンポイント・アドバイス
ご使用の際は、マスクから10~15cm離して、マスクの外側と内側それぞれに3~4回プッシュするだけで、十分な量をまんべんなく付着させることができます。また、スプレーした後は、よく乾かしてからご使用ください。1~2分ほどで乾きます。

本品はアルコールを含んでおります。
●アルコールに敏感な方、特に肌の弱い方は使用しないでください。●スプレーしたマスクはよく乾かしてから使用してください。


受験本番に向けて、お子さまだけでなく、家族みんなで風邪やインフルエンザの元となるウイルス・菌の感染を防がなければなりません。そのためには、正しい知識が必要です。感染対策やウイルス・菌による病気のより詳しい情報は、「ウイルス・菌対策研究所」のサイトをチェックしましょう。ウイルス・菌への予防策も分かりやすく解説しています。

こわーいウイルス・菌を寄せ付けない! マスクの正しい使い方
今回は、マスクによる風邪やインフルエンザの予防を効果的にするEtakを配合した防菌スプレーを紹介しました。連載第1回「本番で力を発揮するための風邪予防法」では、マスクの正しい使い方をわかりやすく説明しています。お子さまの体調管理もエデュママの大事な役割です。健康のプロによる正しい知識を活かして、風邪予防を心がけましょう。







